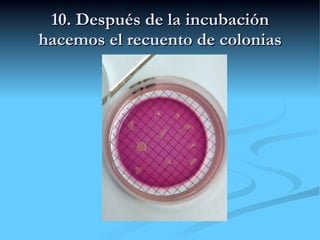
10. Después de la incubación hacemos el recuento de colonias

Incrustar presentación
Descargado 24 veces












El documento describe los pasos para filtrar 100 ml de agua contaminada con coliformes usando un filtro de microfiltración de 0,45 μm para atrapar los microorganismos, los cuales son luego cultivados en un medio VRBL e incubados a 37°C para contar las colonias y analizar el agua.